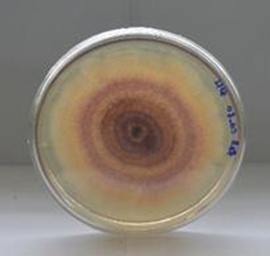

https://doi.org/10.35381/a.g.v7i12.4442
Caracterización cultural, morfológica y fisiológica de Fusarium spp. en pitahaya, Palora, Ecuador
Cultural, morphological and physiological characterization of Fusarium spp. in pitahaya, Palora, Ecuador
Karina María Elena Carrera-Sánchez
Universidad Estatal Amazónica, Puyo, Pastaza
Ecuador
https://orcid.org/0000-0003-1438-4466
Edison Roberto Suntasig-Negrete
Universidad Estatal Amazónica, Puyo, Pastaza
Ecuador
https://orcid.org/0000-0002-4908-6795
Paul Marcelo Manobanda-Pinto
Universidad Estatal Amazónica, Puyo, Pastaza
Ecuador
https://orcid.org/0000-0003-0207-9229
Javier Dominguez-Brito
Universidad Estatal Amazónica, Puyo, Pastaza
Ecuador
https://orcid.org/0000-0001-6508-9198
Recibido: 13 de septiembre 2024
Revisado: 8 de noviembre 2024
Aprobado: 9 de diciembre 2024
Publicado: 01 de enero 2025
RESUMEN
El trabajo tuvo por objetivo determinar la caracterización cultural, morfológica y fisiológica in vitro, de Fusarium spp., agente causal de la marchitez vascular de pitahaya amarilla (Hylocereus spp), en la Región Amazónica del Ecuador. Se recolectaron raíces de 8 fincas en el cantón Palora. Se realizaron aislamientos que fueron evaluados e identificados mediante caracterización cultural, morfológica y fisiológicas. Para los ensayos se utilizaron medios de cultivo semi sólido (PDA y CLA) y medio de cultivo líquido PDB. La velocidad de crecimiento radial fue de 2,8 mmxdía-1 de los aislados, independientemente de su procedencia. No se encontraron diferencias significativas en la caracterización cultural en cuanto al borde y textura de las colonias entre los aislados. Se detectaron variaciones en su coloración, observándose colores rojos, rojo pálido, rojo amarillento hasta el rosa claro. No se observaron diferencias significativas en cuanto al tamaño de microconidias, macroconidios y conidióforos, determinándose que el pH 7 es el óptimo para el desarrollo de Fusarium spp.
Descriptores: Fusarium; caracterización; pitahaya amarilla; Ecuador. (Tesauro AGROVOC).
ABSTRACT
The objective of this work was to determine the cultural, morphological and physiological in vitro characterization of Fusarium spp. the causal agent of vascular wilt of yellow pitahaya (Hylocereus spp) in the Amazon region of Ecuador. Roots were collected from 8 farms in the Palora canton. Isolations were evaluated and identified by cultural, morphological and physiological characterization. Semi-solid culture media (PDA and CLA) and PDB liquid culture media were used for the tests. The radial growth rate was 2.8 mmxday-1 of the isolates, regardless of their origin. No significant differences were found in the cultural characterization in terms of colony border and texture among the isolates. Variations were detected in their coloration, with red, pale red, yellowish red to light pink colors. No significant differences were observed in the size of microconidia, macroconidia and conidiophores, determining that pH 7 is the optimum for Fusarium spp. Development.
Descriptors: Fusarium; characterization; yellow dragon fruit; Ecuador. (AGROVOC Thesaurus).
La fruta del dragón, también conocida como pitahaya, es producida por un cactus tropical trepador del género (Hylocereus) y es un miembro de las cactáceas (He et al., 2012). Estas frutas son autóctonas del continente americano de la región andina y se encuentra distribuida geográficamente en Bolivia, Perú, Ecuador, Colombia y Venezuela (Suárez Román, 2012). Hay tres especies que tienen frutos comerciales valiosos tales como Hylocereus undatus de cascara roja, carne blanca (Hunt, 2006); Hylocereus polyrhizus (Britton y Rose) cáscara roja y carne roja; e Hylocereus megalantus (Ralf Bauer) con cascara amarilla, carne blanca (Wiwik et al., 2013).
Según Suárez Román (2012), la pitahaya es importante como cultivo debido a su amplia variabilidad en cuanto a forma y tamaño del fruto, esquejes, colores de cáscara, la pulpa y a sus períodos de fructificación. Es considerado un frutal exótico por su sabor, apariencia, calidad y propiedades nutraceúticas; con potencial de mercado a nivel nacional e internacional. En Ecuador el cultivo de pitahaya es relativamente nuevo, pero actualmente existen grandes extensiones de cultivo localizadas en la provincia de Guayas con la producción de H. undatus, en Pichincha el H. megalantus y en Morona Santiago el Hylocereus spp.
Desde hace unos diez años, en el cantón Palora, provincia de Morona Santiago, inició el cultivo de pitahaya como alternativa de diversificación de productos para el consumo local, nacional y posible exportación, para generar ingresos económicos y mejorar la calidad de vida de los agricultores. En la actualidad tiene mayor importancia porque la fruta está posicionada en el mercado nacional e internacional (Vargas et al., 2020). Hace unos años se identificó una variedad de pitahaya endémica de la Amazonía ecuatoriana llamada ecotipo Palora, de la cual no existe un estudio botánico ni fito patogénico para determinar la especie correspondiente.
En el cantón Palora las plantaciones de pitahaya iniciaron como una actividad económica alternativa; en la actualidad existen aproximadamente 1.200 hectáreas sembradas y en producción; con aproximadamente 228 productores dedicados como única actividad económica. La fruta se comercializa en el cantón en centros de acopio quienes ofertan al mercado nacional y exportan a Estados Unidos, Canadá, Hong Kong, Singapur, España, Francia y Malasia convirtiéndose el cultivo en una actividad económica importante de la zona.
Por su interés económico se ha intensificado la producción cubriendo extensiones considerables de terreno en monocultivo de la misma manera incrementando problemas fitosanitarios que afectan el rendimiento y la calidad de la fruta, sin ninguna información científica acerca de la determinación de agentes causales. Actualmente se han detectado en el cultivo síntomas como clorosis general de la planta, enanismo, marchitamiento, lesiones café oscuras en los tallos junto con zonas cloróticas y muerte vascular. Sin embargo, por similitud a los síntomas se presume la presencia del hongo Fusarium. Además, las condiciones climatológicas del cantón registran una humedad relativa promedio del 85% y una temperatura promedio de 24 °C; condiciones propicias para la proliferación de hongos. En este sentido, González et al. (2012) informan que la infección por nematodos formadores de agallas causa cambios fisiológicos en la raíz, lo que provoca como consecuencia la resistencia al hongo Fusarium spp. La presencia de patógenos en el suelo es inherente por su historial de uso con cultivos de naranjilla.
Fusarium es un género que causa enfermedades en muchos cultivos como la Pitahaya. En el caso de F. oxysporum causa podredumbre basal, además son teteectados el F. fujikuroi, F. proliferatum en Malasia y F. solani de Bali, Indonesia (Ratankumar et al., 2013).
La pudrición basal inicia con una lesión amarilla en el tallo, en el sitio de unión del fruto con la penca, causando en el fruto apariencia de madurez prematura. La infección avanza hacia el centro del fruto, produciendo pudrición parcial, y afectando hasta el 50% de la superficie. Finalmente, se observa pudrición blanda o seca de color marrón en la base del fruto. La enfermedad se hace más evidente cuando se acerca la cosecha (Salazar González et al., 2016).
La pitahaya es una especie que no presenta similitud de manejo con otras plantaciones de importancia económica. Los productores del cantón Palora han desarrollado tecnologías de manejo empíricas con programas fitosanitarios no específicos para los agentes causales de las enfermedades. El uso inadecuado de pesticidas puede causar resistencia de los patógenos y residualidad de ingredientes activos en la fruta, ocasionando pérdidas económicas que actualmente se combate retirando la planta con raíz del cultivo y replantando sin previo tratamiento del suelo.
Es por ello que resulta importante el estudio de este patógeno; se pone a disposición de la comunidad científica una colección de cultivos de Fusarium spp. adecuadamente caracterizadas. Así mismo, se demuestra que el agente causal de marchitez vascular de pitahaya lo constituye Fusarium spp. Con esta caracterización e identificación del causante de la enfermedad se reducirá las pérdidas económicas de los productores, ocasionadas por este hongo fitopatógeno en las plantaciones de pitahaya.
En la investigación se presenta un primer reporte científico de este fito patógeno, el fusarium spp., en pitahaya en la Amazonia ecuatoriana. En base a la problemática, se propuso como objetivo determinar las características culturales, morfológicas y fisiológicas in vitro de Fusarium spp., agente causante del marchitamiento vascular de la pitahaya (Hylocereus spp.), en el cantón Palora, Morona Santiago, Ecuador.
MÉTODO
Se seleccionan ocho fincas de productores de pitahaya en el Cantón Palora, provincia de Morona Santiago, de la Región Amazónica ecuatoriana (Figura 1).

Figura 1. Mapas de: Ecuador, Morona Santiago y Ubicación de las fincas.
Elaboración: Los autores.
En las fincas se realizó muestreo dirigido a las plantas con síntomas de marchitez vascular, de manera aleatoria de las diferentes parroquias del cantón (Tabla 1).
Tabla 1.
Plantaciones de producción de pitahaya muestreadas.
|
Finca |
Provincia |
Cantón |
Sector |
Propietario |
|
1 |
Morona Santiago |
Palora |
Comanche |
Claus Díaz |
|
2 |
Morona Santiago |
Palora |
Sangay |
Jorge Hidalgo |
|
3 |
Morona Santiago |
Palora |
Nuevo Amundalo |
María Milán |
|
4 |
Morona Santiago |
Palora |
16 de Agosto |
Manuel Sarmiento |
|
5 |
Morona Santiago |
Palora |
Nuevo Amundalo |
Wilson Rivadeneira |
|
6 |
Morona Santiago |
Palora |
Arapicos |
Ana Rojas |
|
7 |
Morona Santiago |
Palora |
Madre Selva |
Gabriel Cruz |
|
8 |
Morona Santiago |
Palora |
Paquisha |
Hugo Quispe |
Elaboración: Los autores.
El trabajo se realizó en el laboratorio de microbiología de la Universidad Estatal Amazónica, ubicada en Puyo, provincia de Pastaza, Ecuador.
Para el desarrollo de la investigación se usaron:
· Tijeras de podar,
· fundas plásticas,
· bolsas de papel kraf,
· cajas Petri de 90 mm Ø, marca Senna modelo 3-61015,
· Erlenmeyer de 500 y 1 000 mL de marca CITOGLAS,
· lámpara de alcohol, sacabocados de 7 y 4 mm,
· embudo de malla artesanal,
· navaja,
· aza de inoculación,
· vasos de precipitación de 25 ml y 250 mL de marca OBEROI,
· porta objetos de marca ALFALAB, modelo CAT. NO.7105 y dimensiones de 76,2 X 25,4 mm (1”X3”),
· cubre objetos de marca B&C GERMANY, dimensiones 22 x 22 mm, probetas marca GLASSCO de 500 mL,
· frascos lavadores de 500 mL, bisturí # 20,
· calibrador pie de rey marca TRUPER,
· parafilm marca BEMIS, de dimensiones 4INx125 FT. ROLL,
· papel filtro marca WHATMAN de 125 mm Ø.
· Microscopio estereoscopio marca MOTIC, modelo DM143;
· microscopio óptico marca MOTIC, modelo Q720AD SERIES B1 con cámara digital incorporada con el software MOTIC images plus 2.0 ml, modelo MULTI LANGUAGE;
· cámara de flujo laminar LABCONCO;
· incubadora marca MEMMERT, modelo INB 400;
· estufa marca MEMMERT;
· autoclave 121 °C (con una presión de 0.7–1 bar) marca WISE CLAVE;
· cámara de fotos marca CANNON;
· balanza analítica marca AE ADAM;
· plato agitador marca IKA;
· multiparametro marca SARTORIUS;
· ultra congelador marca Daihan Scientific;
· refrigerador de marca INDURAMA;
· cámara neubauer.
Medios de cultivos:
· Potato Destroxe agar (PDA) TMMEDIA,
· Potato Dextrose Broth (PDB) DIFCO.
· Medio de cultivo Carnation Leaf-Piece Agar (CLA): 10 g de Agar (Difco), pedazos de hoja de clavel estéril, esto sea aforó a 500 mL de agua destilada.
Recolección de muestras con síntomas de marchitez vascular:
Las muestras de plantas de pitahaya recolectadas fueron las que presentaban síntomas de marchitamiento vascular en pitahaya mediante un muestreo sistemático desarrollado. Se recolectó una muestra por finca y se colocaron en bolsas de papel que fueron trasladadas al laboratorio. Las muestras fueron separadas según sus síntomas y fueron codificadas de acuerdo de la finca de procedencia (Figura 2).

Figura 2. Síntomas de marchitez vascular agente causal de Fusarium spp. en pitahaya.
Elaboración: Los autores.
Para dar cumplimiento a los postulados de Koch se propuso la metodología para el aislamiento y obtención de cultivos puros de Fusarium spp.
· Identificación de micobiota asociada a raíz de pitahaya
Se tomaron segmentos de raíz de 0,3 a 0,5 cm con partes de tejido enfermo y sano, y se lavaron con agua corriente durante 5 min con el uso de un tamiz metálico. Los fragmentos se desinfectaron en agitación continua con alcohol al 70% durante 3 min y nuevamente se agitaron en un Erlenmeyer con agua estéril durante 2 min. Los segmentos desinfectados se colocaron en cajas de Petri que contenían papel filtro humedecido con agua estéril. Dichas cajas de Petri conformaban las cámaras húmedas y se incubaron a 26 ±2 °C durante 48 horas.
Transcurrido este tiempo se aislaron los hongos filamentosos por medio del examen bajo el microscopio óptico y la ayuda de un asa previamente esterilizada. Bajo el microscopio estereoscopio binocular se realizó la siembra directa en placas de Petri, que contenían 16 mL de medio de cultivo CLA (Sosa Sánchez et al., 2022). La identificación se realizó teniendo en cuenta los criterios morfológicos (conidias y clamidosporas) acorde a lo referido por Nelson et al. (1983) y Leslie y Summerell (2006). Para la observación de las estructuras morfológicas se usó un microscopio óptico, con un aumento de 100 X. Se han obtenido cultivos mixtos de hongos y bacterias que forman el microbiota de raíz de pitahaya.
· Aislamiento de Fusarium spp.
A partir de cultivos mixtos se aislaron Fusarium spp. de cultivos previamente establecidos se tomaron esporas las cuales fueron colocados en placa de Petri que contenían 16 mL del medio de cultivo semisólido PDA y se incubaron a 25 ± 2 °C durante 15 días. Transcurrido este tiempo se seleccionaron las colonias típicas de Fusarium spp. con el uso de claves taxonómicas según Leslie y Summerell (2006).
· Obtención de cultivos puros de Fusarium spp.
Se tomó una muestra de tejido vascular de cada finca siendo los tratamientos con 12 repeticiones a nivel de laboratorio para la caracterización cultural, morfológica y fisiológica; a los 21 días se observaron en el microscopio óptico y se identificaron los aislados de Fusarium spp. Las colonias fueron purificadas en repiques consecutivos en cajas de Petri con medio semi sólido PDA. Una vez purificados los aislamientos se almacenaron en incubadora a 25 ± 2 °C en medio de cultivo CLA, durante 15 días.
· Conservación de Fusarium spp.
Los aislados de Fusarium spp. fueron sembrados en cajas de Petri que contenían medio de cultivo semi-sólido PDA. Transcurridos 20 días de su crecimiento, se procedió a conservarlos. Se utilizaron 8 tubos Eppendorf de 2 mL por aislado. En autoclave, se esterilizó agua destilada y glicerol al 15%, a una temperatura de 121 °C y 1 atm por 15 min. Dentro de la cámara de flujo laminar se procedió a colocar 6 mL de agua destilada estéril con 6 mL de glicerol en 8 tubos Eppendorf.
Con la ayuda de un sacabocados de 4,30 mm de diámetro se colocó dos discos de micelio en cada Eppendorf y se los selló con parafilm. Se procedió a conservar los aislados a una temperatura de -4 ±2 °C, posteriormente se pusieron en el ultra congelador temperatura de -80 ±2°C hasta su empleo.
· Identificación de aislados de Fusarium spp.
Cada aislado monospóricos de Fusarium spp. previamente obtenidos se subcultivó en cajas de Petri (90 mm Ø) contentivas de 16 mL de PDA (Leslie y Summerell, 2006), se inocularon en el centro de caja de Petri con un disco de micelio de 7 mm de cada uno de los aislados. Fueron incubados a 25 ± 2 °C en condiciones de oscuridad, durante dos semanas. La caracterización cultural se realizó por medio de un análisis cualitativo y cuantitativo. Se utilizó un diseño completamente aleatorizado donde los aislados fueron ocho tratamientos con 12 repeticiones.
La evaluación del color del anverso y reverso de la colonia, bordes y textura, presencia de líquidos de transpiración se realizó por observación visual de las colonias según lo especificado en trabajos realizados por Wiwik et al. (2013) y Chehri et al. (2014). Las mediciones fueron registradas diariamente, hasta que la placa Petri estuvo completamente cubierta. Se evaluó el crecimiento micelial (Ø de la colonia mm) con la ayuda de un calibrador digital mediante el cálculo de la tasa de crecimiento radial TCR (mm.día-1) propuesta por Baldrian y Gabriel (2002) (ecuación 1).
[1]
Donde: DF: Diámetro final (mm); Di: Diámetro inicial (mm); Tf: Tiempo final (días); Ti: Tiempo inicial (días).
Para procesar la información de las variables color del anverso y reverso de la colonia, bordes, textura, presencia de líquido de transpiración, se utilizó la Estadística Descriptiva, y se realizaron gráficos de distribución de frecuencias.
La variable crecimiento micelial de las colonias (mm) se comparó entre los ocho tratamientos mediante ANOVA con la prueba Tukey (P=0,05), previa comprobación de los supuestos de normalidad de los datos y homogeneidad de varianzas demostrando independencia en las muestras. Para todos los análisis se utilizó el paquete estadístico IBM SPSS Statistic versión 21,0.
· Caracterización aislados de Fusarium spp. en base a su morfología
Se cultivaron cuatro aislados que mostraron mayor crecimiento micelial en la caracterización cultural en medio de cultivo CLA se aforó a 500 mL de agua destilada, la solución se trasvasó a un Erlenmeyer de 1 000 mL para la esterilización en la autoclave a 121 °C y 1 atm por 15 minutos. Se realizaron 12 repeticiones que fueron colocados en la incubadora a temperatura de 25 °C durante 7 días, según lo sugerido por Leslie y Summerell (2006) y Chehri et al. (2015).
A partir de los 7 días, se iniciaron las evaluaciones con el microscopio óptico invertido, se tomaron imágenes digitales con la cámara acoplada. Se usó un aumento de 100X. Mediante esta técnica se determinaron las dimensiones (µm) de conidióforos, microconidias y macroconidios.
Para la caracterización morfológica de los aislados se observaron a través de la técnica de montaje mediante cinta adhesiva del aislado y se tuvieron en cuenta los criterios descritos por Leslie y Summerell (2006), para la identificación morfológica. Se midió el largo por la zona más gruesa (µm) de 150 estructuras tomadas aleatoriamente, de cada una de los aislados.
Para el conteo de las esporas, se adicionó 1 mL de agua estéril con 0,1 µL de Tween 80, en tubos de ensayo de 10 mL con un disco de micelio de 4,3 mm de cada caja de Petri. Después se colocaron en el agitador vórtex, hasta que la suspensión se dispersó completamente en el medio, luego se tomaron 20 µL con la pipeta y se colocaron en la Cámara de Neubauer, para determinar la concentración final de conidios por mL. La fórmula para el cálculo fue la reportada por Bastidas (2009).
Donde: C: concentración; Número de esporas: Suma de todas las células contadas en todos los cuadros; Número de cuadros: Cuadros de Cámara de Neubauer; Disolución: Para una dilución de 1: 10. Dilución = 0,1.
· Caracterización para aislados de Fusarium spp. en base a su fisiología
Para la caracterización fisiológica, se utilizó el aislado que mostró mayor crecimiento micelial en la caracterización morfológica.
· Influencia del pH en el crecimiento micelial de Fusarium spp.
El ensayo se realizó con el objetivo de determinar la influencia del pH de incubación sobre crecimiento de Fusarium spp. Se utilizó el medio de cultivo líquido PDB (Potato Dextrosa Broth), con una dosis de 3,6 g en 150 mL de agua destilada, que se dispensó en un Erlenmeyer de 500 mL y esterilizó en autoclave a 121 °C y 1 atm por 15 min. El medio fue vertido en Erlenmeyer de 100 mL de capacidad, bajo la cámara de flujo laminar.
En este medio se sembraron discos de micelio con la ayuda de un sacabocados de 4 mm de diámetro y una aguja de inoculación, el ajuste del pH se realizó antes de esterilizarlo, se modificaron con HCl a 0,001 M, en un rango de pH desde 4 a 7 con una escala de 1 entre pH, con 12 repeticiones por aislado, y se mantuvieron en la incubadora a temperatura de 25 °C durante 21 días. Posteriormente el micelio crecido en medio líquido se filtró em papel filtro estéril y posteriormente se pesó el micelio, colocando en papel filtro para obtener el peso seco del micelio del aislado.
RESULTADOS
Se obtuvo un total de ocho aislados que corresponden con el género Fusarium spp. procedentes de plantaciones de pitahaya del cantón Palora, provincia de Morona Santiago.
Los aislados más frecuentes a partir de plantas afectadas fueron los de Fusarium spp. Estuvieron presentes en todas las de fincas objeto de estudio, donde se pudo identificar que las colonias de estos aislamientos presentaron coloraciones que variaron desde el rojo, rojo pálido, rojo amarillento hasta el rosa claro. Las mismas presentaron bordes regulares y textura algodonosa, con líquidos de transpiración (Figura 3).
Figura 3. Cultivos puros de Fusarium spp. procedentes de plantaciones de pitahaya del cantón Palora, provincia de Morona Santiago.
Elaboración: Los autores.
Los conidios fueron fácilmente separables y con paredes gruesas, de forma oval, elíptica, con un largo de 43,52 µm. Los aislados cumplieron los postulados de Koch, lo que evidenció su identidad.

Figura 4. Macroconidios y clamidosporas de Fusarium spp. micrografía con aumento de 1000X.
Elaboración: Los autores.
Durante el aislamiento de Fusarium spp. se identificó el género de hongos anamorfos asociado a raíces enfermas con síntomas de marchitez vascular, correspondiente al género: Aspergillus niger (P.E.L.van Tieghem) procedentes del cantón Palora. De este hongo fue posible observar esporas e hifas septadas, no se determinaron las dimensiones de las estructuras (Figura 5 a y b).

Figura 5. A) Esporas de A. niger en medio PDA. b). Microfotografía con aumento de 1000X.
Elaboración: Los autores.
Las características de Fusarium spp. y A. niger. coincidieron con las descritas por Duarte Leal et al. (2016), quienes identificaron los géneros Fusarium y Aspergillus en la micobiota en garbanzo (Cicer arietinum L.) en Cuba. En la micobiota asociada se pudo observar con la presencia de bacterias Gram (-), pues se identificaron colonias similares a puntos blancos incluidos en el medio de cultivo PDA, en las placas de Petri corroborando por lo descrito por Ríos et al. (1997) en el cultivo de H. undatus.
Identificación de aislados de Fusarium spp. en pitahaya en base a sus características culturales
Todas las colonias de los aislados fueron capaces de crecer de forma radial y sus características culturales fueron similares en medio PDA a 25 ± 2 °C. La velocidad de crecimiento radial fue de 2,8 mm.día-1 presentando los aislados UEA-Fsp4 de Paquisha y UEA-Fsp6 de 16 de Agosto la mayor velocidad de crecimiento micelial a los 18 días de incubación difiriendo significativamente con los demás aislados.
A su vez los aislados UEA-Fsp1 Arapicos, UEA-Fsp2 Comanche y UEA-Fsp3 Madre Selva demostraron tener un crecimiento radial similar entre si finalizando su crecimiento a los 21 días en las mismas condiciones. Mientras que los aislados UEA-Fsp5 Numbayme, UEA-Fsp7 y UEA-Fsp8 Amundalo no pudieron colonizar en su totalidad la caja de Petri a los 21 días de incubación.
Estos resultados están cercanos a los informados por Wiwik et al. (2013), quienes determinaron que la velocidad de crecimiento radial fue de 3,74 - 4,45 mm cada 3 días al estudiar el patógeno Fusarium. solani Mart., una enfermedad responsable de la podredumbre en Hylocereus spp. en Bali.
Difiriendo con Rodríguez Velásquez (2013) quien obtuvo valores de 90 mm en 10 días de Fusarium spp procedente de Physalis peruviana L. en medio PDA a 25 ºC. La velocidad de crecimiento de los aislados de Fusarium procedentes de pitahaya pudiera estar directamente relacionada con la colonización del suelo, aspecto que se debe esclarecer en investigaciones futuras.
Las tonalidades de colores observados en el anverso y reverso de los aislados tuvieron una considerable variabilidad que fue de rojo, rojo pálido, rojo amarillento hasta el rosa claro. Los pigmentos generales no son indicadores para determinar una especie, las colonias de este hongo fitopatógeno tienen una considerable variabilidad en cuanto a tonos de coloración de micelio que varía del rojo, marrón, violeta, naranja, amarillo hasta el blanco según lo manifestado por Nelson et al. (1983) y Leslie y Summerell (2006). Concordando con los resultados de Madhukeshwara (2001) quien obtuvo coloraciones de rojo oscuro hasta amarillo pálido de F. oxysporium de Cajanus cajan L. (Huth); y Chandran y Kumar (2012) quienes obtuvieron coloraciones rosas pálido y rojo oscuro de F. solani en cítricos.
Los aislados UEA-Fsp2, UEA-Fsp4, UEA-Fsp6 y UEA-Fsp8 presentaron una tonalidad de color rojo pálido en su crecimiento, mientras que los aislados UEA-Fsp1 y UEA-Fsp5 color rojo. A su vez el aislado UEA-Fsp7 presentó una coloración amarillo rojizo. El aislado UEA-Fsp3 inicialmente tuvo una coloración blanca y terminó su desarrollo con coloración rosa claro diferenciándose de los demás aislados, lo cual coincide con lo informado por Duarte Leal et al. (2016) para Fusarium spp. en Cicer arietinum L.
Todos los aislados de Fusarium spp. en pitahaya al finalizar su crecimiento presentaron bordes regulares, textura algodonosa y líquidos de transpiración incoloros. Debido a la homogeneidad no se encontraron diferencias entre aislados.
Característica descrita por Ochoa et al. (2000) quien al determinar el color de F. oxysporum en Carica x heilbornii var. Pentagona. Duarte Leal et al. (2016) en Fusarium spp. de Cicer arietinum L. coinciden con los resultados de esta investigación al describir coloraciones que variaron desde violáceo a ligeramente amarillenta, de blanquecino a rojo ladrillo. Mientras que Lezcano et al. (2012) manifiesta que Fusarium spp posee un micelio aéreo y afelpado en Leucaena leucocephala Lam. de igual manera lo describe Shanhnazi et al. (2012) en Piper nigrum L.
Caracterización asilados de Fusarium spp. en pitahaya en base a su morfología
Los aislados UEA-Fsp2, UEA-Fsp4 y UEA-Fsp6 fueron los que presentaron mayor crecimiento micelial en la caracterización cultural de Fusarium spp. y se emplearon para realizar la caracterización morfológica. Los aislados presentaron microconidias, macroconidias y clamidosporas que corresponden con las características descritas por Nelson et al. (1983) y Leslie y Summerell (2006) para Fusarium spp.
Las características morfológicas de los aislados de Fusarium spp. en medio CLA fueron similares. En este medio se desarrollan tanto micelio como conidios para todos los aislados; similar a lo reportado por otros autores quienes en sus trabajos han usado este medio de cultivo (Schroers et al., 2009; Chehri et al., 2015). Las microconidias tuvieron una forma ovalada, elíptica usualmente sin septos, sus células conidiogencias fueron monofiliales cortas, presentaron abundante micelio aéreo (Figura 6).

Figura 6. Microconidias de Fusarium spp. de forma ovalada y elíptica perteneciente al aislado UEA-Fsp4 en medio CLA a los 8 días de incubación microfotografía con aumento de 1000 X.
Elaboración: Los autores.
Los macroconidios presentaron una morfología corta a media longitud, sus paredes fueron ligeramente curvadas, relativamente delgadas, sus formas apicales fueron curvas y a veces presentaron un ligero gancho, la morfología de células basales fueron de pie en forma puntiaguda, generalmente presentaron tres a cuatro septos, se encontraron en hifas en crecimiento en la superficie del agar (Figura 7).

Figura 7. Macroconidios de Fusarium spp. del aislado UEA-Fsp4 en medio CLA a los 14 días de incubación, microfotografía con aumentos de 1000X.
Elaboración: Los autores.
Las clamidosporas son de paredes lisas, generalmente se encontraron en pares y en cadenas cortas, se encuentra intercaladas en hifas sumergidas y aéreas (Figuras 8).

Figura 8. a) Clamidosporas de Fusarium spp del aislado UEA-Fsp4. b) UEA-Fsp6 en medio CLA a los 18 días de incubación microfotografía con aumento de 1000X.
Elaboración: Los autores.
La mayoría de aislados produjeron microconidias de forma ovalada, elíptica (38–43 µm de largo), obtenidas en medio de cultivo CLA. Este resultado es confirmado por Schroers et al. (2009), Duarte Leal et al. (2016) quienes describieron formas de microconidias de ovaladas y elípticas de Fusarium spp en medio de cultivo CLA.
Concordando con los resultados informados por Chehri et al. (2014) quienes presentan resultados similares al desarrollo de Fusarium spp en Malaysa con microconidias (20 µm) y macroconidias con tres septos (50 µm). Además, Dubey et al. (2010) describieron dimensiones cercanas en la descripción taxonómica de F. oxysporum f. sp. ciceris en medio de cultivo CLA en India con microconidias (30 µm) y macroconidias con tres septos de igual manera con la forma y dimensiones de microconidias y macroconidias de esta investigación.
Se muestran las dimensiones correspondientes al largo promedio de las microconidias de los aislados obtenidos de Fusarium spp. Se aprecia que el aislado que presentó la mayor longitud promedio de microconidias fue de UEA–Fsp6 con un valor de 43,52 µm seguido por UEA–Fsp2 con 43,31 µm estadísticamente similares, difiriendo significativamente del aislado UEA–Fsp4 con el menor valor de 30,09 µm.
Las dimensiones gráficas se muestran el largo promedio de las macroconidias de los aislados obtenidos de Fusarium spp., donde se aprecia que el aislado que presentó el mayor valor promedio para el largo de macroconidias promedio fue UEA–Fsp4 con un valor de 152,02 µm difiriendo significativamente de los aislados UEA–Fsp2 con un valor de 144,46 µm y UEA–Fsp6 con un valor de 145,79.
Las dimensiones gráficas muestran el largo promedio de las clamidosporas de los aislados de Fusarium spp. las que fueron estadísticamente diferentes, siendo el aislado UEA–Fsp2 con un valor de 71,71 µm el que presentó el mayor valor para el largo promedio de clamidosporas seguido por el aislado UEA–Fsp4 con un valor de 66,54 µm y del aislado UEA–Fsp6 con un valor de 59,18 µm.
Según Lezcano et al. (2012), al caracterizar el Fusarium de semillas de Leucaena leucocephala, describieron macroconidias semi curvas con tres a cinco septos de 26,10–36,74 µm y microconidias ovaladas a elípticas con dimensiones de 3,58–4,06 µm lo que difiere con las dimensiones de las microconidias de esta investigación.
Duarte Leal et al. (2016), obtuvieron valores medios para las macroconidias de F. oxysporum muy próximos a los del presente trabajo, en un aislado del sector Paquisha. Las características de las microconidias y clamidosporas de los aislados corresponden con los descritos por Leslie y Sumer (2006) para la especie de F. oxysporum quienes describieron las microconidias de morfologías apicales curvas con tres septos y clamidosporas de paredes lisas.
Contrario a estos resultados Kawuri et al. (2012) verificaron que las microconidias presentaron 4,6 µm, macroconidias con 31 µm y clamidosporas de 5–15 µm en la caracterización morfológica de F. oxysporum en Aloe barbadensis en Indonesia. Al igual Wiwik et al. (2013) informa que F. solani en Hylocereus spp. presento macroconidias de 18,4–31,7 µm, curvadas con 3 septos y microconidias de 5,7 y 5,8 µm ovaladas ensayos realizados en medio de cultivo PDA.
Para la concentración de conidios existen diferencias significativas entre aislados.El aislado UEA–Fsp4 presentó mayor cantidad de conidios, seguido por los aislados UEA–Fsp2 y UEA-Fsp6. Esto es confirmado por Leslie y Summerell (2006) que describen dimensiones cercanas en la descripción taxonómica de F. oxysporium.
Caracterización para aislados de Fusarium spp. en base a su fisiología
El aislado UEA–Fsp4 correspondiente a la finca del sector Paquisha fue el que presentó mayor crecimiento micelial en la caracterización cultural de Fusarium spp. y fue el seleccionado para realizar los ensayos de esta caracterización.
Influencia de pH en el crecimiento micelial
Se observó el crecimiento micelial del aislado UEA-Fsp4 en todos los valores de pH evaluados (desde 4,0–7,0), siendo el pH 7 que produjo mayor peso del micelio obtenido valores de 0,34 g, seguido del pH 6 con un valor de 0,30 g y el pH 4 y 5 con valores similares entre sí de 0,2 g. (Figura 9).
Figura 9. Dinámica de peso de micelio en diferentes pH de Fusarium spp. de pitahaya en medio de cultivo PDB a los 21 días de incubación a 25 ± 2 °C.
Elaboración: Los autores.
Orozco de Amezquita et al. (1993) mencionaron que en condiciones controladas a F. oxysporum como agente causal del marchitamiento vascular del clave Dianthus caryophyllus L. creció fácilmente en un intervalo de pH entre 4,0 a 7,0. El desarrollo micelial necesita de pH entre 5,0 y 7,0 mientras que para la formación de conidios requiere pH 6,5 concordando por los resultados de la presente investigación.
CONCLUSIONES:
Las características culturales, morfológicas y fisiológicas de los ocho aislados obtenidos con síntomas de Marchitez vascular de Hylocereus spp. se correspondieron al género Fusarium spp.
Los caracteres culturales de los aislados UEA-Fsp2, UEA-Fsp4 y UEA-Fsp6 demostraron óptimo crecimiento en medio de cultivo semisólido PDA a los 18 días de incubación, con una velocidad de crecimiento de 2,88 mm.día-1. Las tonalidades del color de los aislados variaron según los días de crecimiento, observándose tonalidades de rojo a rosa claro, presentaron borde regular y textura algodonosa.
En los caracteres morfológicos se observó microconidios ovales, elípticos, sin septos; macroconidias con tres a cuatro septos y clamidosporas de paredes lisas intercaladas en hifas, con dimensiones promedio de 43,52; 152,02 y 71,71 µm respectivamente.
El óptimo pH para el desarrollo micelial fue de 7 en cuanto a sus caracteres fisiológicos.
FINANCIAMIENTO
Autofinanciado.
AGRADECIMIENTO
A todos los agentes sociales involucrados en el desarrollo de la investigación.
REFERENCIAS CONSULTADAS
Baldrian, P., y Gabriel, J. (2002). Intraspecific variability in growth response to cadmium of the wood-rotting fungus Piptoporus betulinus. Mycologia, 94(3), 428-300. https://pubmed.ncbi.nlm.nih.gov/21156514/
Bastidas, O. (2009). Technical Note-Neubaver Chamber Cell Counting. https://n9.cl/wfxp8
Chandran, R., y Kumar, R. (2012). Studies on cultural, morphological variability in isolates of Fusarium solani (Mart.) Sacc., incitant of dry root-rot of Citrus. Current Biotica, 6(2), 152-162. https://n9.cl/vppv5l
Chehri, K., Salleh, B., y Zakaria, L. (2014). Morphological and Phylogenetic Analysis of Fusarium solani Specie Complex in Malaysia. Microbial Ecology, 69(3), 457-471. https://doi.org/10.1007/s00248-014-0494-2
Dubey, S. C., Shingh, S. R., y Shingh, B. (2010). Morphological and pathogenic variability of India isolates of Fusarium oxysporum f.sp. ciceris causing chickpea wilt. Archives of Phytopathology and Plant Protection, 43(2), 174-190. https://doi.org/10.1080/03235400802021108
Duarte Leal, Y., Echevarría Hernández, A., y Martínez Coca, B. (2016). Identificación y caracterización de aislamiento de Fusarium spp. presentes en garbanzo (Cicer arietinum L.) en Cuba. Revista Protección Vegetal, 31(3), 173-183. https://n9.cl/9k0gg
González, I., Arias, Y., y Peteira, B. (2012). Aspectos generales de la interacción Fusarium oxysporum f. sp. Lycopersici–tomate. Revista de Protección Vegetal, 27(1), 1-7. https://n9.cl/eae6n
He, P., Ho, H., Wu, H. M., y He, Y. (2012). Bipolaris cactivora causing fruit rot of dragon fruit imported from Vietnam. Plant pathology y Quarantine, 2(1), 31-35. https://doi.org/10.5943/ppq/2/1/5
Hunt, D., Taylor, N., y Graham Ch. (2006). The New Cactus Lexicon. DH Books. https://n9.cl/nub3s
Kawuri, R., Suprapta, D. N., Nitta, Y., y Homma, T. (2012). Destructive Leaf Rot Disease Caused by Fusarium oxysporum on Aloe barbadensis Miller in Bali. Agricultural Science Research Journal, 2(6), 295-301. https://n9.cl/jlzifi
Leslie, J. F., y Summerell, B. A. (2006). The Fusarium Laboratory Manual. Blackwell Editorial. https://doi.org/10.1002/9780470278376
Lezcano, J., Martínez, B., y Alonso, O. (2012). Caracterización cultural y morfológica e identificación de diez aislamientos de Fusarium procedentes de semillas de Leucaena leucocephala cv. Perú. Pastos y Forrajes, 35(2), 187-196. https://n9.cl/zig9z
Madhukeshwara, S., y Seshadri, V. S. (2001). Varation and management of Fusarium Wilt of Pigeon Pea (Cajanus cajan (L.). Tropical Agricultural Research, 13, 380-394. https://n9.cl/ha9c4
Nelson, P. E., Tousson, T. A., y Marasas, W. F. O. (1983). Fusarium species: An Illustrated Manual for Identification. Pennsylvania State University Press. https://n9.cl/opazx
Ochoa J., Fonseca G., y Ellis, M. (2000). First report of Fusarium wilts of babaco of Babaco (Carica x heilbornii var. pentagona) in Ecuador. Plant Disease, 84(2), 199. https://doi.org/10.1094/PDIS.2000.84.2.199A
Orozco de Amezquita, M., Garcés de Granada, E., y Arbelaéz, G. (1993). Efecto de diferentes niveles de nitrógeno, potasio y pH en el desarrollo de Fusarium oxysporium f.sp. dianthi, agente causal del marchitamiento vascular del clave. Agronomía colombiana, 10(1), 90-102. https://n9.cl/xd1ge6
Ratankumar, A., Susheel, K., Vishambhar, D., Sudip, K., Singh, S., Sumitra, T., Boopathi, L., Saurav, S., Priyanka, I., Sushanti, T., Emekamwamut, N. (2023). Fusarium equiseti as the pathogen causing stem rot disease of red-fleshed dragon fruit (Hylocereus polyrhizus) in India. Crop Protection, 173, 106380. https://doi.org/10.1016/j.cropro.2023.106380
Rodríguez Velásquez, E. (2013). Caracterización de aislamientos de Fusarium spp. obtenidos de zonas productoras de uchuva (Physalis peruviana) en Cundinamarca y Boyacá. [Tesis de Maestría; Universidad Nacional de Agronomía], Repositorio Institucional UNAL. https://n9.cl/wjqvi
Ríos, G., Villavicencio, A., Guevara, V., Pichardo, S. (1997). Estudio epidemiológico y etiológico de la bacteriosis de la pitahaya Hylocereus undatus Britton and Rose, Smith y su efecto sobre variedades del cultivo. [Trabajo de grado, Universidad Nacional Agraria] Repositorio Institucional RiUNA. https://n9.cl/gdik5
Salazar González, C., Serna Cock, L., & Gómez López, E. (2016). Molecular characterization of Fusarium associated with basal rot of thefruit of pitahaya (Selenicereus megalanthus). Agronomía Mesoamericana, 27(2), 277-285. https://doi.org/10.15517/am.v27i2.21269
Schroers, H. J., O’Donnell, K., Lamprecht, S. C., Kammeyer, P. L., Johnson, S., Sutton, D. A., Rinaldi, M. G., Geiser, D. M., & Summerbell, R. C. (2009) Taxonomy and phylogeny of the Fusarium dimerum species group. Mycologia, 101(1), 44-70. https://doi.org/10.3852/08-002
Sosa Sánchez, O., Romero Bastidas, R., Silva Pupo, J., Gaibor Fernández, R., Rodríguez Rodríguez, R, & Ceiro Catasú, W. (2022). Caracterización cultural-morfométrica como herramienta para la identificación de Fusarium spp., asociado a Nicotiana tabacum L. Agronomía Costarricense, 46(1),111-128, 2022. https://doi.org/10.15517/rac.v46i1.49872
Suárez Román, R. S. (2012). Caracterización morfoanatómica y fisiológica de semilla sexual de pitahaya amarilla Selenicereus megalanthus (Haw.) Britt & Rose. Revista de la Asociación Colombiana de Ciencias Biológicas, 1(24), 97-111. https://n9.cl/vlu2w
Vargas, Y., Pico, J., Díaz, A., Sotomayor, D., Burbano, A., Caicedo, C., Paredes, N., Congo, C., Tinoco, L., Bastidas, S., Chuquimarca, J., Macas, J., & Viera, W. (2020). Manual Técnico del cultivo de pitahaya. INIAP. https://n9.cl/3rx4p
Wiwik, S. R., Suprapta, D. N., Sudana, M., & Swantara, M. D. (2013). First report on Fusarium solani, a pathogenic fungus causing stem rot disease on dragon fruits (Hylocereus sp.) in Bali. J. Biol. Agric. Healthcare 3, 93-99. https://n9.cl/sbvdt